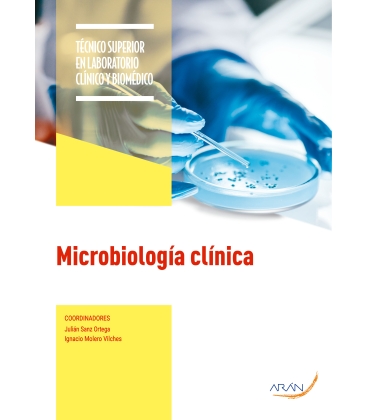
Microbiología clínica

Carrito
0
0
elemento(s)
-
0,00 €
Sin productos
Por determinar
Envío
0,00 €
Total
Cantidad
Total
Producto añadido correctamente a tu carrito
Hay 0 elementos en tu carrito.
Hay 0 elementos en tu carrito.
Total